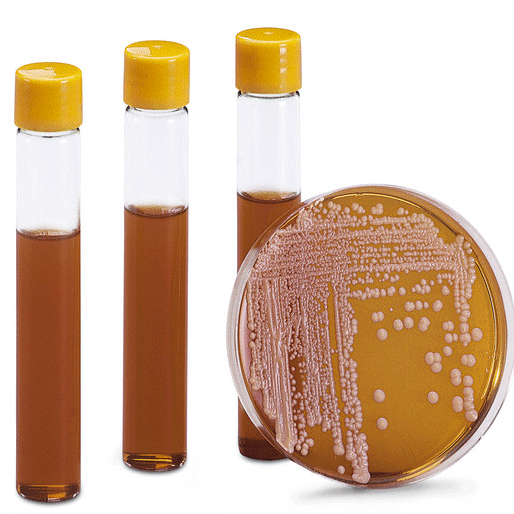

病理
[展开描述+]病理
-
产品货号
产品名称
产品描述
-
对软骨细胞和肥大细胞进行染色
-
常用于丝绸、纸张、细菌、细胞等染色
-
在染细胞和植物组织上应用极广
-
在染细胞和植物组织上应用极广
-
一种结合多阴离子的阳离子染料
-
一种结合多阴离子的阳离子染料
-
对于观察新型隐球菌有很好的作用
-
可用于用于细胞脱落标本
-
本染色液经过滤除菌,可以直接用于培养细胞的染色
-
用于实验动物或较小的组织块的标记
-
NADH-TR染色,可使I型肌纤维呈深蓝紫色
-
染料染色法,用于活细胞染色及计数
-
应用于研究外源基因瞬时表达转化实验
-
适用于植物种子活力的染色

